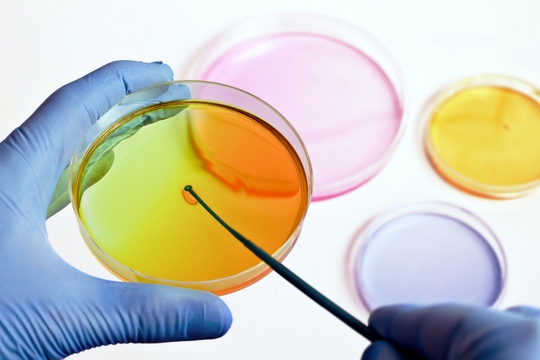

香港衞生署衛生防護中心於二月時公佈愛滋病的最新感染數字。不說不知,原來上一年的愛滋病病毒感染數字共559宗,是有記錄以來最多。自1984年起,本港感染愛滋病病毒累積個案達6,342宗,平均每年200多宗感染。2013年愛滋病病發新症則有84宗,1984年至今共累積了1,437宗病發個案。

衞生署衞生防護中心顧問醫生黃嘉慶引述報告指出,性接觸,尤其是男男性接觸,仍然是愛滋病的主要傳播途徑。在559宗新呈報個案中,295人透過同性或雙性性接觸感染,137人透過異性性接觸感染。

愛滋病感染者 將終身帶毒
愛滋病學名為「後天免疫力缺乏症」,是由一種名為「人類免疫力缺乏病毒」(HIV)所引致。當受到愛滋病病毒感染,病毒會破壞「CD4 T淋巴細胞白血球」,削弱免疫系統,令身體無法抵抗各種感染和癌症。一旦感染愛滋病病毒,身體將永遠帶有病毒,如沒得到適當的治療,平均五成的愛滋病病毒感染者會在10年內演變成愛滋病病人。藥物治療能令大多數愛滋病病毒感染者活得更久,承受較少痛苦。

愛滋病檢測方法
及早得知受感染,可盡早接受治療,減低愛滋病病發機會。現時有3種常見的檢驗愛滋病病毒方法,包括:

「愛滋病病毒RNA測試」及「愛滋病病毒超高靈敏度RNA測試」並非以愛滋病抗體為檢測對象,因為愛滋病抗體是在感染後一段特定時間後才會產生,這兩種測試並不能肯定確診患者是否在一段長時間以前便受感染,較難追蹤感染源頭,但能在受感染後短時間內確定到患者是否受感染。
「愛滋病病毒抗原及抗體測試」可同時檢測病毒抗原及抗體,因此這測試能肯定確診患者是在一段長時間以前便受感染,較容易追蹤感染源頭。另外,在感染一段時間後,愛滋病病毒抗原數量會下降,而抗體數量則會上升,同時檢測抗原及抗體可確保測試準確性。
每種測試方法所需的病毒檢測量及空窗期不一,詳情如下。

1. 愛滋病病毒RNA測試
RNA測試主要檢測愛滋病病毒的基因物質(即愛滋病病毒本身),較愛滋病病毒抗體更早於感染初期透過血液檢測得到。
感染愛滋病病毒多久才可檢測:11至15日
RNA最低檢測量:不少於100 copies/ml
2. 愛滋病病毒超高靈敏度(Ultra-sensitive)RNA測試
超高靈敏度RNA測試用於檢測感染初期的愛滋病病毒。相比RNA測試,它能檢測更早期的愛滋病病毒感染。
感染愛滋病病毒多久才可檢測:7日
RNA最低檢測量:25 copies/ml

3. 愛滋病病毒抗原及抗體測試
當愛滋病病毒感染人體後,免疫系統會開始製造抗體。雖然這些抗體並不能抵禦病毒入侵,但仍可幫助診斷身體是否染上愛滋病病毒,化驗結果通常需時數天。凡呈陽性的測試結果,都必須進行第2次測試,以確認測試結果無誤。
感染愛滋病病毒多久才可檢測:16至19日
抗原最低檢測量:約10,000 copies/ml
抗體最低檢測量:約100,000 copies/ml

定期驗身 保障性福
本港去年感染愛滋病病毒個案共559宗,較前年升近兩成,而13年的感染數量又較12年多,說明感染愛滋病病毒個案於近年有上升趨勢。所以,只要曾有性行為,便應定期接受愛滋病病毒檢測,以保障個人及伴侶的健康。如欲查詢更多愛滋病檢測詳情,請按這裡。
http://health.esdlife.com/bodycheck-plan/std-check-mhs.php
延伸閱讀

